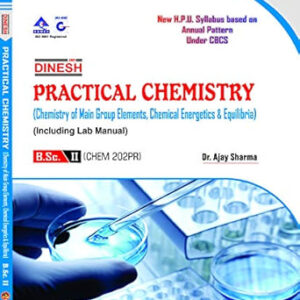
Practical Chemistry (Chemistry of Main Group Elements, Chemical Energetics & Equilibrium) B.Sc. IInd Year H.P.U.

Uncategorized
Showing 87–88 of 121 results
-
Practical Chemistry (Chemistry of Main Group Elements, Chemical Energetics & Equilibrium) B.Sc. IInd Year H.P.U.
₹210.00 Add to cart -

Practical Chemistry (Chemistry of Transition and Inner Transition Elements, Coordination Chemistry, Organometallics, Acids and Bases) (Including Lab Manual) B.Sc- 3rd Year
₹195.00 Add to cart


